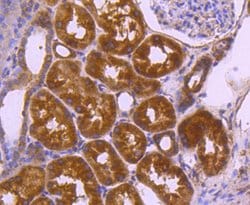
Invitrogen VEGF Recombinant Rabbit Monoclonal Antibody (SP07-01) 100 &mu;L;

Learn More
Invitrogen™ VEGF Recombinant Rabbit Monoclonal Antibody (SP07-01)
Rabbit Recombinant Monoclonal Antibody
Brand: Invitrogen™ MA532038
Description
Recombinant rabbit monoclonal antibodies are produced using in vitro expression systems. The expression systems are developed by cloning in the specific antibody DNA sequences from immunoreactive rabbits. Then, individual clones are screened to select the best candidates for production. The advantages of using recombinant rabbit monoclonal antibodies include: better specificity and sensitivity, lot-to-lot consistency, animal origin-free formulations, and broader immunoreactivity to diverse targets due to larger rabbit immune repertoire.
VEGF (vascular endothelial growth factor) which is a 45 kDa homodimeric, disulfide-linked glycoprotein involved in angiogenesis which promotes tumor progression and metastasis. VEGF has a variety of effects on vascular endothelium, including the ability to promote endothelial cell viability, mitogenesis, chemotaxis, and vascular permeability. The VEGF family currently includes VEGF-A, VEGF-B, VEGF-C, VEGF-D, VEGF-E, and PIGF. VEGF and its receptor system have been shown to be the fundamental regulators in the cell signaling of angiogenesis. Most tumors have the absolute requirement of angiogenesis, and VEGF has been described as the most potent angiogenic cytokine linked to this process. To date 5 different isoforms of VEGF have been described. These isoforms are generated as the result of alternative splicing from a single VEGF gene. These various isoforms have been shown to bind to two tyrosine-kinase receptors flt-1 (VEGFR-1) and flk-1/KDR (VEGFR-2), which have been found to be expressed almost exclusively on endothelial cells. VEGF and its high-affinity binding receptors, the tyrosine kinases FLK1 and FLT1, are thought to be important for the development of embryonic vasculature. Studies have shown that an alternately spliced form of FLT1 produces a soluble protein, termed sFLT1, which binds vascular endothelial growth factor with high affinity, playing an inhibitory role in angiogenesis. Elevated levels of VEGF is linked to POEMS syndrome (Polyneuropathy, Organomegaly, Endocrinopathy, Monoclonal gammopathy, Skin changes) also known as Crow-Fukase syndrome which affects multiple organs in the body.
Specifications
| VEGF | |
| Recombinant Monoclonal | |
| 1 mg/mL | |
| TBS with 40% Glycerol, 0.05% BSA and 0.05% sodium azide; pH 7.4 | |
| P15692, P16612, Q00731 | |
| VEGFA | |
| Synthetic peptide within Human VEGF aa 183-232. | |
| 100 μL | |
| Primary | |
| Human, Mouse, Rat | |
| Antibody | |
| IgG |
| Flow Cytometry, Immunohistochemistry (Paraffin), Western Blot, Immunocytochemistry | |
| SP07-01 | |
| Unconjugated | |
| VEGFA | |
| angiogenic factor; etID309976.16; eVEGF120; eVEGF164; human VEGF121 homolog; MGC70609; MVCD1; ovine vascular endothelial growth factor; RP1-261G23.1; unnamed protein product; VAS; vascular endothelial growth factor; vascular endothelial growth factor (VEGF) precursor; vascular endothelial growth factor 121 isoform; vascular endothelial growth factor 164; vascular endothelial growth factor 165b; vascular endothelial growth factor 182; vascular endothelial growth factor 182 isoform; vascular endothelial growth factor 188; vascular endothelial growth factor 188 isoform; vascular endothelial growth factor 189; vascular endothelial growth factor A; vascular endothelial growth factor A121; vascular endothelial growth factor A165; vascular endothelial growth factor Aa; Vascular endothelial growth factor A-A; vascular endothelial growth factor isoform 165; vascular permeability factor; Vasculotropin; VEGF; VEGF1; VEGF164; VEGF182; VEGF188; vegfa; VEGF-A; VEGFA165b; vegfaa; VEGF-A-A; VEGFMGC70609; VPF; VPF ant; wu:fj82c06 | |
| Rabbit | |
| Protein A | |
| RUO | |
| 22339, 7422, 83785 | |
| Store at 4°C short term. For long term storage, store at -20°C, avoiding freeze/thaw cycles. | |
| Liquid |
Your input is important to us. Please complete this form to provide feedback related to the content on this product.